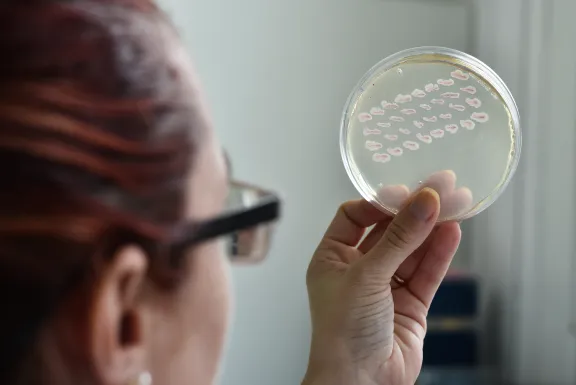
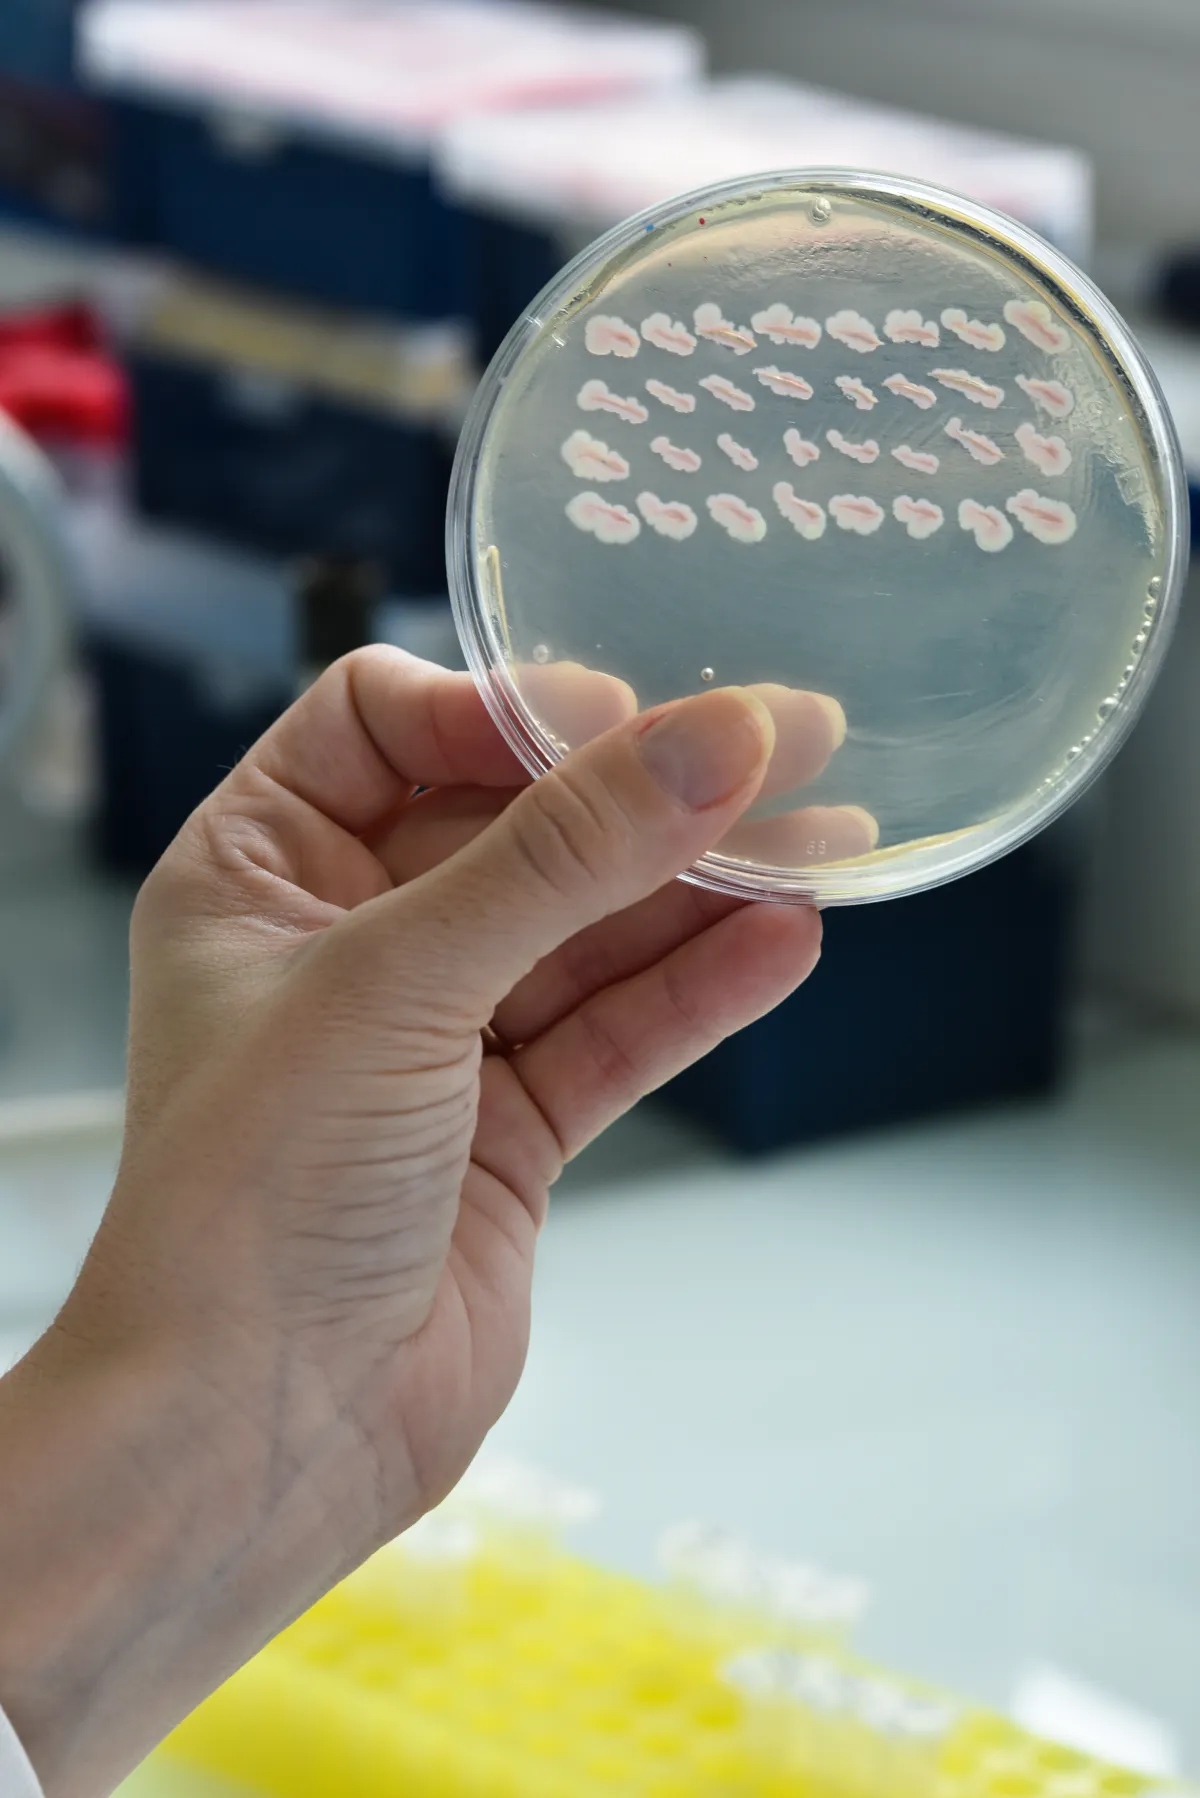

Eric Cascales Un harpon microscopique, arme secrète des bactéries
Éric Cascales, directeur de recherche au CNRS
- 2018 • Prix Bettencourt Coups d’élan pour la recherche française

Méditerranée (IMM) à Marseille, en octobre 2018. ©Gil Lefauconnier

Méditerranée (IMM) à Marseille, en octobre 2018. ©Gil Lefauconnier
À l’Institut de Microbiologie de la Méditerranée, l’équipe d’Éric Cascales décrypte les rouages d’un nano-harpon utilisé par certaines bactéries pathogènes dans une lutte acharnée pour un territoire de choix : notre corps.
T6SS : une arme fatale
Poisons, grenades, mines et harpons : tous ont leur équivalent microscopique dans le monde bactérien où se livre une guerre sans répit pour le territoire et l’accès aux nutriments. Dans ce surprenant arsenal, une arme est minutieusement décortiquée par l’équipe d’Éric Cascales depuis plusieurs années : le système de sécrétion de type VI ou T6SS. Composé d’une plateforme sur laquelle s’insère un tube surmonté d’un pic et entouré d’une gaine contractile, le T6SS s’apparente à un harpon dont la flèche est propulsée par un ressort. Des bactéries telles que celles responsables du choléra ou de certaines salmonelloses se servent du T6SS pour injecter directement leurs toxines dans le cytoplasme de leurs concurrentes.
Mieux comprendre la virulence bactérienne
L’équipe, en utilisant comme organisme modèle une souche d’Escherichia coli entéro-agrégative, a découvert récemment que cette bactérie pathogène utilise son harpon T6SS contre ses compétitrices directes, celles utilisant les mêmes sources de nutriments que dans les intestins humains. Le T6SS serait donc un instrument de colonisation, première étape indispensable à la virulence bactérienne.
Le soutien de la Fondation
Avec le soutien du Prix Bettencourt Coups d’élan pour la recherche française, le groupe d’Éric Cascales va s’équiper d’un microscope à fluorescence, afin de pouvoir suivre l’assemblage et la dynamique de leur arme bactérienne. L’achat d’équipements de culture cellulaire et d’un puissant cluster de calcul finaliseront l’installation de l’équipe dans ses nouveaux locaux. En développant de nouvelles méthodes de recherche, ils espèrent décrire la variation d’une espèce à l’autre du complexe membranaire qui attache le harpon à la cellule. Leurs travaux porteront sur la dynamique d’assemblage et la structure de la plateforme sur laquelle repose le harpon, ainsi que sur le mécanisme de contrôle de l’extension de la gaine contractile, garant de la puissance de propulsion de la flèche du harpon.
Eric Cascales en quelques mots
Dès sa thèse de doctorat, Éric Cascales s’enthousiasme pour les moteurs moléculaires bactériens, les abordant à la fois sur le plan fonctionnel et sur le plan structural. Son post-doctorat, dans la continuité de sa thèse, s’intéresse aux systèmes de sécrétion bactériens. À la suite de ces travaux, Éric Cascales définit donc tout naturellement son projet de recherche : l’étude des transports bactériens et des machineries associées.
Dès la création de son équipe, il la rassemble autour du système de sécrétion de type VI. Alors que l’étude de cette nano-arme bactérienne n’est que depuis peu un intense domaine de recherche en microbiologie, l’équipe compte à son actif plus de 30 publications scientifiques sur le sujet. Combinant des approches de biologie intégrative, biologie structurale, biochimie, génétique et microscopie à fluorescence, l’équipe a d’ores et déjà répondu à un nombre important de questions concernant la régulation, l’assemblage, les mécanismes d’action et l’origine évolutive de l’arme moléculaire T6SS, ainsi que son rôle pour la flore intestinale.

Prix Bettencourt Coups d’élan pour la recherche française
Le Prix Coups d’élan pour la recherche française a été créé par la Fondation en 2000, il a récompensé 78 laboratoires français et plus de 900 chercheurs ont bénéficié de ce prix. Jusqu'en 2021, ce prix était attribué chaque année à quatre équipes de recherche, relevant de l’Inserm et de l’Institut des sciences biologiques du CNRS. La dotation du prix était de 250 000 euros par laboratoire lauréat.
Tous les lauréats du prix